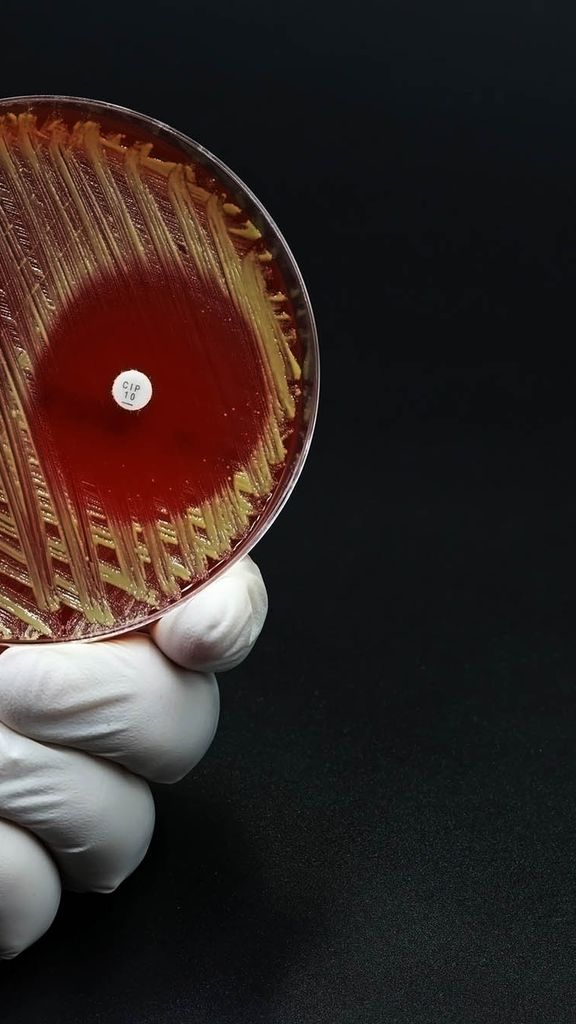
Photo: Stock of a white latex gloved hand holding a Petri dish with a microbiological culture Petri dish with bacteria where an antibiotic resistance test has been carried out.

Latest Headlines
-
 October 28, 2025
October 28, 2025 -

Think Mushrooms Are a Pizza Garnish? You Haven’t Read Spores of Doom
BU’s Aaron Worth compiles weird tales about fungi in new anthology
October 29, 2025 -

BU Men’s and Women’s Cross Country Heading to Patriot League Championships Friday
Terriers say they’re prepared as they go for conference titles
October 28, 2025
Top Stories
-
This Weekend @ BU: October 30 to November 2
Try seasonal crafting, spend the night at the ice rink, or celebrate the fall harvest
October 29, 2025 -
How to Stay Safe (and Still Have Fun) This Halloween
Three tips every BU student should know
October 27, 2025 -
New BU Hub Class Teaches Students How to Navigate the US Healthcare System
Healthcare Literacy 101, a collaboration between former classmates and Student Health Services
October 28, 2025 -
BU’s Annual Security Report Reflects Changing Patterns
The report, mandated by the federal Clery Act, prompts reminders from BUPD to lock doors, be mindful of surroundings, report suspicious behavior
October 28, 2025
Scene at BU

AG Andrea Campbell, Area Law Students in Wide-Ranging Discussion
Massachusetts Attorney General Andrea Campbell (left) met with students from Boston University, Northeastern University, and Western New England University for a fireside chat at the School of Law October 28. They discussed issues affecting the current legal and political landscape, among them immigration, transgender rights, the role of attorneys general in protecting states, and how students can prepare for careers in law. From left: Campbell, Ivana Wijedasa (LAW’26), Tai Walker, Western New England University School of Law, and Diamond Blaylock-Norris, Northeastern School of Law.
Photo courtesy of the Office of Attorney General Andrea Joy Campbell
Featured Events
Get Caught Up
-
National BU-Led Study Finds College Student Mental Health Continues to Improve
BU public health researcher Sarah K. Lipson on decrease in students experiencing depression—and what you can do to support your own well-being
October 27, 2025 -
Wheelock Program Aims to Broaden Who Stands in Front of Classrooms
BU’s Holmes Scholars chapter is part of a national effort to create a more representative educational workforce
October 27, 2025 -
BU Engineer Builds Next-Gen Sensors with Mix of Living Cells and Tiny Electronics
Biomedical engineer Miguel Jimenez blends engineering fields to develop devices to monitor environmental and human health
October 23, 2025

Culture
Get BU Today In Your Inbox
SubscribeBrowse Sections
Arts & Culture
- Zombies Attack BU—in Dear Abbeys New Music Video
- Think Mushrooms Are a Pizza Garnish? You Haven’t Read Spores of Doom
- CFA Play Mixes Generative AI and Shakespeare
Business & Law
- 50 Years After Mandated by US Law, Special Education’s Future in Question, BU Scholar Says
- Communicating Climate Is the Focus of Inaugural Boston University Center for Media Innovation & Social Impact Summit
- Supreme Court Associate Justice Sonia Sotomayor Offers Advice, Insight to BU Law Students at Annual Shapiro Lecture
Campus Life
- BU Field Hockey’s Four Sister Sets
- A Sleepover in the CDS Building? BU Students Will Participate in Weekend-Long Hackathon
- COM Students Help Fill Local News Gap Through Partnership with Boston Neighborhood Network
Health & Medicine
- New BU Hub Class Teaches Students How to Navigate the US Healthcare System
- 9 Mental Health Resources for BU Faculty and Staff
- The Top Five Mental Health Lessons I Gained from Therapy
In the City
- This Weekend @ BU: October 30 to November 2
- How to Stay Safe (And Still Have Fun) This Halloween
- This Weekend @ BU: October 23 to 26
Science & Technology
- Interning at NASA Fulfills a Lifetime Ambition for This CAS Student
- Getting to Know Your Neighborhood: Fort Point/Seaport
- Why Do We Keep Watching Reality Dating Shows?
Sports
- BU Field Hockey’s Four Sister Sets
- BU Men’s and Women’s Cross Country Heading to Patriot League Championships Friday
- Run Your City Boston Teaches Running Skills and Racing to K-8 Athletes
University News
- BU’s Annual Security Report Reflects Changing Patterns
- How to Stay Safe (And Still Have Fun) This Halloween
- Questrom Revises Undergrad Curriculum to Help Students Better Prepare for Internships, Jobs
Voices & Opinion
- How to Stay Safe (And Still Have Fun) This Halloween
- The Top Five Mental Health Lessons I Gained from Therapy
- 10 BU Hacks to Navigate the Student Experience